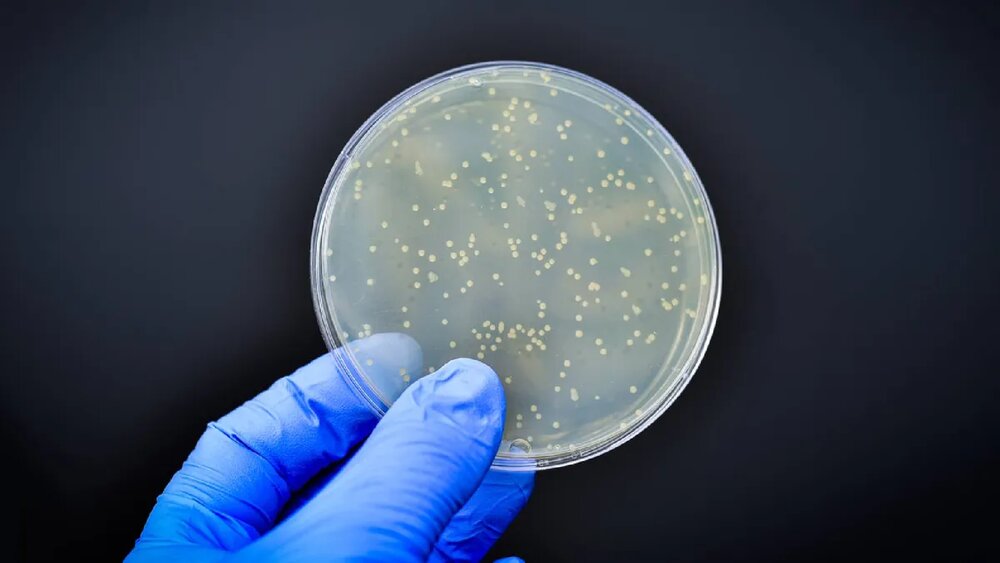

باکتری
-

حفظ کیفیت و افزایش ماندگاری سیلوی علوفهای با فرآورده باکتریایی محققان کشور
محققان پژوهشگاه بیوتکنولوژی کشاورزی موفق به تولید فرآورده باکتریایی با قابلیت حفظ کیفیت و افزایش ماندگاری سیلوی علوفهای شدند که از این محصول با حضور وزیر جهاد کشاورزی رونمایی شد. به گزارش خبرآنی، دکتر صالحی جوزانی، رئیس پژوهشگاه بیوتکنولوژی کشاورزی در این باره اظهار کرد: سالانه بیش از سه میلیون دلار انواع فرآوردههای باکتریایی سیلوهای علوفهای وارد کشور میشود که با تجاریسازی فرمولاسیون ارائه شده توسط محققان پژوهشگاه بیوتکنولوژی کشاورزی که حاصل یک دهه تلاش تحقیقاتی است، زمینه تامین این فرآوردهها در داخل کشور فراهم خواهد شد. وی خاطرنشان کرد: در حال حاضر از حدود ۲۰ میلیون تن علوفه تولیدی در کشور، بیش از ۵۰ درصد (حدود ۱۰ میلیون تن) به صورت سیلویی استفاده میشود که سالانه بین ۱۰ تا ۲۰ درصد این علوفه سیلویی (حدود یک میلیون تن) به دلیل نقص در فعالیت باکتریهای اسید لاکتیک موجود در...
-

زخمپوش نوین آنتیباکتریال با گیاه آویشن ساخته شد
محققان دانشگاه صنعتی امیرکبیر موفق به طراحی و ساخت زخمپوش نوین آنتی باکتریال با قابلیت رهایش عصاره گیاه آویشن شدند. به گزارش خبرآنی، آذین رشیدی احمدی، دانشآموخته دانشگاه صنعتی امیرکبیر و مجری طرح «طراحی و ساخت زخمپوش نوین آنتی باکتریال با قابلیت رهایش عصاره گیاه آویشن» که آن را با راهنمایی دکتر سعید صابر سمندری عضو هیات علمی دانشگاه صنعتی امیرکبیر و همکاری مهندس کاووس رزمجوئی در آزمایشگاه تحقیقاتی مواد مرکب (CRLab) پژوهشکده فناورهای نو دانشگاه صنعتی امیرکبیر به سرانجام رسانده است، گفت: در سالهای اخیر پانسمان و زخمپوشهای متعددی برای درمان زخمهای ناشی از جراحات معرفی شدهاند، اما زخمپوشی که بتواند عملکرد ویژهای در درمان زخم داشته باشد و به بهبود هرچه سریعتر و بهتر زخم بیماران کمک کند، هنوز مورد توجه محققان و پژوهشگران سراسر دنیا است. وی گفت: از سوی دیگر تامین مواد صنعتی...
-

زخم پوش نوین آنتی باکتریال با گیاه آویشن ساخته شد
به گزارش پایگاه خبری خبرآنی به نقل از دانشگاه صنعتی امیرکبیر، آذین رشیدی احمدی دانش آموخته دانشگاه صنعتی امیرکبیر و مجری طرح «طراحی و ساخت زخم پوش نوین آنتی باکتریال با قابلیت رهایش عصاره گیاه آویشن» گفت: در سالهای اخیر پانسمان و زخم پوش های متعددی برای درمان زخم های ناشی از جراحات معرفی شده اند اما زخم پوشی که بتواند عملکرد ویژه ای در درمان زخم داشته باشد و به بهبود هرچه سریعتر و بهتر زخم بیماران کمک کند هنوز مورد توجه محققین و پژوهشگران سراسر دنیا است. وی گفت: از سوی دیگر تامین مواد صنعتی مورد استفاده در ساخت زخم پوش جهت تولید آن در کشور تبدیل به معضلی جدی شده است؛ بنابراین، نیاز رو به افزایش کشور پیرامون زخمپوشهای موثر در درمان انواع جراحات ما را بر آن ساخت تا به ساخت زخم پوشی تهیه شده از پلیمرهای طبیعی و عصاره گیاه آویشن با قابلیت تسریع روند درمان زخم بیاندیشیم. وی گفت: یکی از...
-

افزایش ماندگاری خواص آنتی باکتری منسوجات با پوست مرکبات
گروهی از محققان یکی از شرکت های فناور با استفاده از یک روش سبز مواد آنتی باکتریالی را برای ایجاد خاصیت ضد باکتری در منسوجات به تولید رساندند و برای ایجاد این ویژگی در پارچه به جای آغشته کردن سطح پارچه به مواد نانویی، مواد نانویی را به تار و پود پارچه وارد کرده و از این طریق مشکل از بین رفتن خاصیت نانویی منسوجات با گذشت زمان و در اثر تماس با سطوح را رفع کرده اند. به گزارش خبرآنی، پارچههای اسپانباند یا بافته نشده کاربردهای متعددی از جمله ساخت تجهیزات پزشکی و آرایشی بهداشتی دارند و در صورتی که از این پارچهها در حوزه پزشکی استفاده شود، باید خواص آنتی باکتریالی در آنها ایجاد شود که در نتیجه سطح پارچه به مواد آنتیباکتریال آغشته میشود. یکی از شرکت های فناور برای این منظور به جای استفاده از مواد شیمیایی آنتیباکتریال، نسبت به تولید مواد آنتی باکتریال به روشی سبز و با استفاده از پوست...

-

باکتری های مضر مواد غذایی با ابداع محققان ایرانی از بین می روند
به گزارش پایگاه خبری خبرآنی به نقل از نیواطلس، هرچند وجود روشی ساده که تمام باکتری های مضر در موادغذایی را از بین می برد، بسیار کارآمد است اما سرازیر کردن آنتی بیوتیک ها در مواد غذایی راه حل مناسبی نیست. درهمین راستا زینب حسین دوست و توحید دیدار استاد و استاد یار دانشگاه مک مستر همراه گروهی از محققان یک اسپری جدید ابداع کرده اند که با کمک ویروس های ایمن برای مواد غذایی، باکتری های مضر در آنها را از بین می برند. این اسپری شامل دانه های میکروژل است که از ویروس هایی شناخته شده به نام باکتریوفاژ استفاده می کند. باکتریوفاژ ها برای انسان بی خطر هستند اما می توانند باکتری های دیگر را بکشند و ببلعند. نکته مهم آنکه برخی باکتریوفاژها نوع خاصی از باکتری را طعمه خود می کنند و به عبارت دیگر تمام باکتری های مفید و مضر را یک جا از بین نمی برند. محققان دانشگاه مک مستر با توجه به تحقیقات پیشین خود فرایند...
-

بانداژ زیست سازگار و ضد باکتری تولید شد
به گزارش خبرنگار خبرآنی، ساختار و عملکرد پوست می تواند بر اثر بریدگی، خراش، سوختگی، برش های جراحی و بیماری هایی مانند دیابت دچار اختلال شود. بهبود زخم فرایندی پیچیده و پیوسته است که در نتیجه تعامل میان بافت ها یا سلول های پیوند شده، عوامل رشد، سیتوکین ها (پروتئین هایی که به وسیله سلول ها ترشح شده و پیامی را به دیگر سلول ها منتقل می کنند) و ماتریکس خارج سلولی اتفاق می افتد. محصولاتی که برای پانسمان و تسهیل بهبود زخم تولید می شوند- از جمله پمادها، فوم ها و ژل ها- توسعه یافته اند تا بهبود انواع متفاوت ضایعات پوستی را با افزایش اثر عامل مؤثر بر بهبود آن، تسهیل کنند. زخم های مزمن زخم هایی هستند که به طور طبیعی بهبود نمی یابند و فشار زیادی بر فرد مبتلا و سیستم درمان وارد می کنند. این زخم ها به دلیل پیشرفت ناهنجاری ها یا عدم کارکرد صحیح عوامل رشد کلیدی ایجاد می شوند. تلاش های زیادی برای...
-

استفاده از ویروسها برای دستکاری ژنتیک باکتریها
به گزارش پایگاه خبری خبرآنی به نقل از نیواطلس، کریسپر ابزاری است که به دانشمندان اجازه میدهد تا ویرایشهای دقیقی بر روی ژنوم سلولهای زنده انجام دهند. این کار توسط آنزیمی امکان پذیر میشود که بخشی از DNA را از هدف جدا میکند و به آن اجازه میدهد تا با چیز مفیدتری جایگزین شود. استفاده از این فناوری قدرتمند نه تنها به دانشمندان امکان میدهد راههای جدیدی برای درمان بیماریها بیابند، بلکه از این طریق میتوان محصولات سالمتری را تولید کرد، آفات را کنترل و آلرژن ها را از حیوانات خانگی حذف کرد. در نهایت از این طریق سلولها به رایانههای کوچک تبدیل میشوند. در طبیعت، روش دستکاری ژنتیک کریسپر در ابتدا توسط باکتریها به عنوان مکانیزم دفاعی در برابر ویروسهایی که آنها را شکار میکردند مورد استفاده بود، اما در مطالعه جدید محققان ویروسهای شکارگر باکتری به نام باکتریوفاژها (یا فاژها) را مهندسی ژنتیک...
-

رقابت محققان ایرانی با شرکت سامسونگ برای تولید محافظ گوشی ضدویروس و باکتری
محققان یکی از شرکتهای فناور پوششهای چسبی آنتی ویروس و آنتی باکتریال برای گوشیهای همراه تولید کردهاند که به گفته آنها این محصول ماه آینده روانه بازار خواهد شد. منوچهر منتظری، مدیر عامل این شرکت فناور با بیان اینکه تمرکز فعالیت این شرکت در زمینه تولید مواد بر پایه نانو فناوری است، گفت: تمرکز اصلی تولیدی ما بر روی تولید مواد ضد ویروس است که در این راستا پوشش برچسبی سطوح ضد ویروسی را ارائه کردیم. وی تولید محافظ تلفن همراه ضد ویروس را از جمله محصولات تولیدی این شرکت نام برد و اظهار کرد: این پوشش که دارای تاییدیه سازمان غذا و دارو است، به طور ویژه بر روی ویروسها اثرگذار است و موجب از بین رفتن ویروس از روی گوشیهای تلفن همراه خواهد شد. منتظری با اشاره به ساختار این محافظ، توضیح داد: در ساختار این محصول از ترکیب چهار نانو ذره استفاده شد و...
-

امکان آنتیباکتریال کردن مواد پلاستیکی با محصول ایرانی فراهم شد
یکی از شرکتهای دانشبنیان موادی را برای آنتی باکتریال کردن مواد پلاستیکی تولید کرده است. به گزارش خبرآنی، ریحانه اتفاق، رئیس هیئت مدیره یکی از شرکتهای دانشبنیان گفت: استفاده روزافزون از مواد پلاستیکی در زندگی انسان باعث شده است، سلامتی و بهداشت این مواد بیش از گذشته مورد توجه قرار گیرد؛ از این رو محصولات تولیدی ما کمک میکند تا مواد و محصولات پلاستیکی خاصیت آنتی باکتریال پیدا کنند. برای مثال فرمان یا داشبورد ماشین میتوانند با استفاده از این محصول مبتنی بر نانو فناوری به صورت ضد باکتری عمل کنند. به نقل از مرکز اطلاعرسانی معاونت علمی ریاستجمهوری، وی اکسید روی را از دیگر دستاوردهای دانشبنیان این شرکت نام برد و افزود: این ماده خاصیت ضد باکتری دارد و در تولید محصولاتی مانند کاشی و سرامیک مورد استفاده قرار میگیرد. کاشی و سرامیک دارای یک لایه از این محصول نانو فناوری، بهداشتیتر...
-

ابداع نانوذراتی برای مقابله با باکتری های مقاوم در بیماران سرطانی
به گزارش خبرنگار خبرآنی، تا به امروز احتمال بروز عفونت های مقاوم به باکتری در بیمارستان ها و واحدهای مراقبت های ویژه یکی از نگرانی های اصلی درباره سلامت بیماران سرطان با سیستم ایمنی ضعیف است. در همین راستا گروهی از محققان با همکاری بهرام صالح پژوهشگر ایرانی از روشی نوین برای مقابله با چنین عفونتی استفاده کردند. آنها ویولاسئین و نانوذرات اکسید آهن ابر پارامغناطیس را در نانوذرات اسیدپلی لاکتیک قرار دادند و برای قابلیت های ضد میکروبی و ضدسرطانی آزمایش کردند.ویولاسئین یک رنگدانه بیس ایندول طبیعی با خواص آنتی بیوتیکی است. اشباع مغناطیسی نانوذرات بارگذاری شده به اندازه ای کارآمد بود که این سیستم نانو را به یک گزینه نویدبخش برای هدف گیری مغناطیسی تبدیل کردند. علاوه برآن ویولاسئین آزاد شده از نانوذرات با غلظت ۵۰۰ میکروگرم بر میلیلیتر با موفقیت از رشد ابر میکروب «استافیلوکوکوس اورئوس»...
-

نوشت افزار آنتی باکتریال با فناوری نانو تولید شد
به گزارش خبرنگارمهر، مهزاد مرصاد، مدیر تحقیق و توسعه یک شرکت دانش بنیان گفت: فعالیت اصلی شرکت، تولید نوشتافزار سلامتمحور و آنتیباکتریال بهوسیله مواد نانویی است. وی افزود: این شرکت دانشبنیان مجهزترین آزمایشگاه نوشتافزار در منطقه را در اختیار دارد که آزمایشگاه همکار استاندارد بوده و دارای استاندارد ۱۷۰۲۵ است. به گفته مرصاد، همچنین این شرکت مجهزترین واحدی است که انطباق جوهر و نوک را در منطقه انجام میدهد. وی با اشاره به محصولات تولید شده آنتی باکتریال در این شرکت گفت: گواش ضد خش، ماسههای بازی، پاککن و خودکار آنتیباکتریال از جمله محصولات این شرکت هستند. مدیر تحقیق و توسعه شرکت با اشاره به اینکه محصولات این شرکت تاییدیه نانومقیاس دارد، ادامه داد: وقتی نوشتافزار آنتیباکتریال تولید میشود، به این معناست که اگر این خودکار و پاککن چند ثانیه در دست بگیرید، تمام باکتریهای مضر...
-
پوشش مسی جدید باکتری ها را سریع تر از بین می برد
به گزارش پایگاه خبری خبرآنی به نقل از اینترستینگ انجینرینگ،پوشش مذکور با افزودن ویژگی های از بین بردن باکتری در مقیاس نانو و روی این کار را انجام می دهد. ویژگی های نانو در اینجا به عنوان برجستگی های کوچکی توضیح داده شده اند که با پاره کردن دیواره سلول باکتری ها، آنها را از بین می برند. از سوی دیگر تاثیرگذاری این ویژگی ها با وجود روی بیشتر می شود. این ماده در تماس با مس اکسیده می شود و به از بین بردن باکتری ها با سرعتی بالاتر از مس خالص کمک می کند. کلیفورد در این باره می گوید: استفاده از پوشش مذکور به میزان قابل توجهی ابتلا به عفونت باکتریایی هنگام لمس سطوح در محیط های خدمات درمانی را کاهش می دهد. همچنین این پوشش حاوی مس کمتری نسبت به نمونه های فعلی است و بنابراین قیمت آن ارزان تر خواهد بود. آزمایش ها روی ماده نشان داد پس از یک ساعت ۹۹.۷ درصد از «استافیلوکوکوس اورئوس»( نوعی پاتوژن که به...
-

استقبال بازار از خودکارهای آنتیباکتریال نانویی
گروهی از محققان بعد از تولید خودکارهای آنتیباکتریال و استقبال بازار از این محصول، از نانوذرات آنتیباکتریال در تولید شن بازی برای کودکان استفاده کردند. به گزارش خبرآنی، نیما محمدبیگی، کارشناس بخش تحقیق و توسعه یکی از شرکتهای فناور با اشاره به تولید خودکارهای آنتیباکتریال با بیان اینکه این محصول با استقبال خوبی در بازار مواجه شده است، گفت: در مجموع برای سه محصول "خودکار آنتیباکتریال"، "شنبازی پویا آنتیباکتریال" و "رنگ گواش ضدخش" گواهی نانومقیاس گرفتهایم. وی با بیان اینکه خودکارهای آنتیباکتریال ما پیشفروش شده است، یادآور شد: در مورد شنبازی پویا که آنتیباکتریال است، نیاز به تاییدیه سازمان غذا و دارو است که به دنبال دریافت این مجوز هستیم و به محض دریافت آن میتوانیم تولید را آغاز کنیم. با توجه به این که این شنها معمولا تا ۵ یا ۶ سال زیر دست بچهها دوام دارند و بچهها...
-

مخترع جهانی نوشتافزار آنتی باکتریال کارآفرین برتر شد
به گزارش گروه اجتماعی پایگاه خبری خبرآنی؛ چهاردهمین جشنواره کارآفرینان برتر استان تهران با حضور معاون اجرایی رئیس جمهور، استاندار تهران، معاونین و مدیران کل وزارت تعاون، کار و رفاه اجتماعی، معاونصنایع عمومی وزارت صمت، رئیس و دبیر کانون کارافرینی کشور و مشاور وزیر کشور، برگزار شد. محسن منصوری در این جلسه اظهار کرد: در حال حاضر جامعه فعال کارگری در استان تهران یک سرمایه کمنظیر برای استان و حتی برای کشور به شمار میرود. وی افزود: حلقههای تولید در کشور متعدد و متکثر است و مهمترین آن حضور نیروی زبده، مستعد و انقلابی است که از این قبیل نیروها کم نداریم. استاندار تهران تصریح کرد: در تهران ظرفیتهای خوب و قابل توجهی داریم و کارآفرینان و کارفرماهای خلاق و مستعد بسیاری در این استان وجود دارد. منصوری گفت: باید از این ظرفیتها برای رفع مشکلات استان بهره ببریم و در این مسیر، همه جانبه...
-

کاهش عفونتهای میکروبی و عفونی با سرویس بهداشتی آنتیباکتریال
یکی از شرکتهای صنعتی با استفاده از نانو ذرات سرویسهای بهداشتی ایرانی با خواص آنتیباکتریال تولید و به بازار عرضه کرد که کاربرد آنها مانع از ایجاد بوی نامطلوب میشود. به گزارش خبرآنی، تمیز بودن سرویسهای بهداشتی هنگام استفاده از دستشوییهای عمومی، یکی از دغدغههایی است که باید راهکاری فناورانه برای آن ارائه شود؛ چرا که شیوع عفونتهای قارچی، حساسیتهای پوستی و بیماریهای عفونی و میکروبی از شایعترین عواقب ابتلا به باکتریها در مکانهای عمومی است. در این راستا یکی از شرکتهای فناور تولید کننده محصولات سرامیکی سرویسهای بهداشتی ایرانی با خواص آنتیباکتریال تولید کرده است. این محصول آنتیباکتریال حاوی نانوذرات بوده؛ از این رو دارای سطوحی با قابلیت ضد رشد میکروب است. این گونه سرویسهای بهداشتی با موادی پوشیده میشوند که انواع باکتریها را از بین میبرد. خاصیت آنتی باکتریال مناسب...
-

تولید لباس ایمن برای کنترل تب نوزادان با خاصیت آنتیباکتریال
به گزارش پایگاه خبری خبرآنی به نقل از ستاد توسعه فناوری نانو، یک شرکت دانشبنیان، لباس آنتیباکتریال تبنمای نوزاد تولید کرده است که در صورت بروز تب در کودک، تغییر رنگ میدهد. این شرکت نانومحصولات دیگری نظیر زیرپوش آنتیباکتریال، نانوکلوئید کیتوسان و پودر سیلیکای مزومتخلخل SBA-۱۵ را در لیست محصولات خود دارد. تب، واکنش دفاعی بدن و علامت یک بیماری است و ممکن است به دلایل مختلف ایجاد شود. در کودکان تب میتواند علامت بیماری مهمی باشد، بهخصوص در مواردی که تب طول بکشد یا تکرار شود و اگر در زمان معین تشخیص داده نشود منجر به اتفاقات خطرناک برای کودکان شده و سلامتی ایشان را به خطر بیندازد. با توجه به اینکه بچهها قادر نیستند وضعیت جسمی خود را به خوبی توصیف کنند، شاید تشخیص تب داشتن یا نداشتن کودک، برای پدر و مادر کاری دشوار باشد. اما والدین میتوانند به وسیله لباس کودک تب نما تب فرزند خود را...
-

باتری زیستی از باکتری با شارژ سه هفتهای تولید شد
به گزارش پایگاه خبری خبرآنی به نقل از نیواطلس، تنوع بخشیدن به منابع انرژی بخش مهمی از روند کاهش اتکا به سوختهای فسیلی است و یکی از جایگزینهای قابل استفاده، باکتریهای تولید کننده برق است. مهندسان دانشگاه بینگهمتون آمریکا برای نخستین بار یک باتری زیستی ساختهاند که شامل سه لایه از گونههای مختلف باکتری است که به کمک هم نور خورشید را جذب کرده و الکتریسیته تولید میکنند. گروه سازنده محفظههای حاوی باکتریهای متمایز را در سه لایه روی هم قرار دادند. لایه بالایی، باکتریهای فتوسنتزی را در خود جای داده که انرژی مورد نیاز را از نور خورشید به دست آورده و مولکولهای آلی تولید میکردند که باکتریهای لایههای زیرین را تغذیه میکنند. باکتری موجود در لایه زیرین باکتری است که از طریق خوردن مواد مغذی و به کمک برخی از مواد شیمیایی تولید شده توسط باکتریهای لایه میانی، الکتریسیته تولید میکند. گروه...
-

فرشهای ضد باکتری با فناوری نانو تولید شد
به گزارش پایگاه خبری خبرآنی به نقل از معاونت علمی و فناوری ریاست جمهوری، یکی از دغدغههای تولیدکنندگان فرش، تامین همه نیازهای مصرفکنندگان و افزایش کیفیت محصولات تولیدی است. فرش از جمله اقلامی است که به دلیل نفوذ باکتری در آن می تواند به بروز حساسیت و آلرژی منجر شود به خصوص پس از شست و شو و رطوبتی که به آن نفوذ میکند؛ اما صنعتگران با کمک فناوری نانو این چالش را رفع و با کمک فناوری نانو، فرش ضدباکتری تولید کردند. استفاده از خاصیت ضدمیکروبی و طبیعی نانو ذرات نقره در تولید و بافت فرش به دلیل برخورداری از خواص مهمی چون ضدقارچ، ضدبو و ضدحساسیت بودن، برای بیماران و افراد دارای حساسیتهای پوستی، چشمی و تنفسی بسیار مفید است و به دلیل تماس مستمر کودکان و افراد خانواده با فرش، سطح سلامتی افراد جامعه را افزایش میدهد. به طور کلی میکروبها، باکتریها و میکروارگانیسمها مانند کورینه باکتریوم...
-

باکتریهای مرتبط با تهاجم سرطان پروستات کشف شدند!
به گزارش خبرنگار اجتماعی پایگاه خبری خبرآنی؛ دانشمندان باکتریهای مرتبط با سرطان تهاجمی پروستات را در تحقیقات خود کشف کردهاند که به عنوان یک انقلاب بالقوه برای پیشگیری و درمان کشندهترین شکل این بیماری شناخته میشود. "گاردین" در این باره نوشت: محققان به سرپرستی دانشگاه "آنگلیا" تجزیه و تحلیلهای ژنتیکی پیچیدهای را بر روی ادرار و بافت پروستات بیش از 600 مرد مبتلا به سرطان پروستات و بدون سرطان پروستات انجام دادند و پنج گونه از باکتریهایی را یافتند که با پیشرفت سریع این بیماری مرتبط هستند. این مطالعه ثابت نمیکند که باکتریها باعث تحریک یا تشدید سرطان پروستات میشوند اما اگر تحقیقاتی که اکنون در حال انجام است نقش آنها را تأیید کند، محققان میتوانند آزمایشهایی را برای شناسایی مردانی که بیشتر در معرض خطر هستند ایجاد کرده و به طور بالقوه آنتیبیوتیکهایی را برای جلوگیری از مرگ هزاران...
-

کشف روش جدید مقابله با مقاومت باکتریهای مرگبار
به گزارش پایگاه خبری خبرآنی به نقل از نیواطلس، باکتریهای مقاوم به آنتیبیوتیک در دهههای آینده به یکی از مهمترین مشکلات برای حفظ سلامتی تبدیل میشوند، زیرا پیشبینی میشود که این ابر میکروبها تا سال ۲۰۵۰ سالانه جان ۱۰ میلیون نفر را بگیرند. محققان دانشگاه تگزاس در آستین راه جدیدی برای مبارزه با این باکتریهای جان سخت پیدا کردهاند. آنها پروتئینی را که باکتریها از آن برای ایجاد مقاومت دارویی استفاده میکنند، هدف قرار دادهاند. ظهور ابر میکروبها نمونه بارز تکامل جهان است. زمانی که بیمار آنتیبیوتیک مصرف میکند، بیشتر باکتریهایی که بدن را آلوده میکنند در برابر محیط چالش برانگیزی که این داروها ایجاد میکنند تسلیم میشوند، اما تعداد معدودی از باکتریها که زنده میمانند به تولید مثل ادامه میدهند و جهشهای تصادفی خود برای زنده ماندن را به دیگر باکتریها منتقل میکنند....





